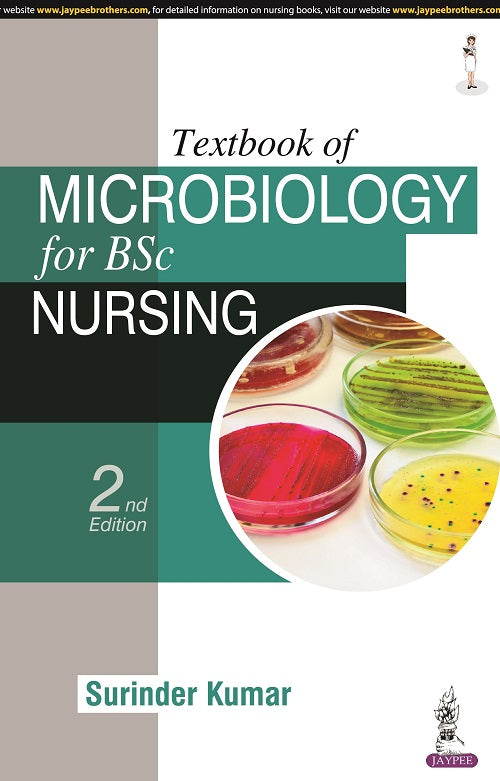
TEXTBOOK OF MICROBIOLOGY FOR BSC NURSING 2/E R.P., 2024, SURINDER KUMAR

- Made With Love
- Made With Love
- Made With Love
- Made With Love
- Made With Love
Recommended Products

TEXTBOOK OF MICROBIOLOGY FOR BSC NURSING 2/E R.P., 2024, SURINDER KUMAR
Regular price
Rs. 625
Sale price
Rs. 425